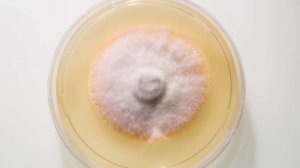
Поражает пах и ягодицы: опасный грибок стремительно распространяется по Европе

0:37
0:37
2025-11-25 16:11

 0:32
0:32

 0:32
0:32
2025-11-25 16:10

 0:43
0:43
0:43
0:43
2025-11-25 15:42

 0:36
0:36

 0:36
0:36
2025-09-28 10:31

 11:32
11:32

 11:32
11:32
2025-09-28 04:36

 0:36
0:36

 0:36
0:36
2025-09-28 14:17

 30:40
30:40

 30:40
30:40
2025-09-28 17:06

 0:45
0:45

 0:45
0:45
2025-09-27 18:31

 1:07:40
1:07:40

 1:07:40
1:07:40
2025-09-27 15:59

 10:49
10:49

 10:49
10:49
2025-09-28 17:01

 6:25
6:25

 6:25
6:25
2025-09-27 21:40

 5:12
5:12

 5:12
5:12
2025-09-27 17:53

 53:43
53:43

 53:43
53:43
2025-09-27 09:00

 24:02
24:02

 24:02
24:02
2025-09-28 10:23

 11:34
11:34

 11:34
11:34
2025-09-28 18:36

 52:24
52:24

 52:24
52:24
2025-09-28 12:00

 23:12
23:12

 23:12
23:12
2025-09-27 15:02

 10:13
10:13
![Enrasta - Франция (Премьера клипа 2025)]() 2:44
2:44
![RRuslan - Снова ночь (Премьера клипа 2025)]() 3:05
3:05
![Искандар Шокалонов - Севгани бор уни Онажон (Премьера клипа 2025)]() 3:05
3:05
![Владимир Ждамиров, Игорь Кибирев - Тик так (Премьера 2025)]() 3:30
3:30
![Ozoda - Chamadon (Official Video 2025)]() 5:23
5:23
![Ксения Рат - Этажи (Премьера клипа 2025)]() 2:37
2:37
![KhaliF - Я розы тебе принес (Премьера клипа 2025)]() 2:06
2:06
![Абрикоса, GOSHU - Удали из памяти (Премьера клипа 2025)]() 4:59
4:59
![Леся Кир - Альфонс (Премьера клипа 2025)]() 3:23
3:23
![ARTEE - Ты моя (Премьера клипа 2025)]() 3:31
3:31
![Алмас Багратиони - Дети света (Премьера клипа 2025)]() 2:52
2:52
![АКУЛИЧ - Красные глаза (Премьера клипа 2025)]() 2:13
2:13
![Азамат Исенгазин - Мой свет (Премьера 2025)]() 2:47
2:47
![Бунёд Бобокулов - Отам-онам (Премьера клипа 2025)]() 4:00
4:00
![Ахрор Гуломов - Ёмгирлар (Премьера клипа 2025)]() 3:49
3:49
![Маша Шейх - Будь человеком (Премьера клипа 2025)]() 2:41
2:41
![Рейсан Магомедкеримов - Моя мадам (Премьера клипа 2025)]() 3:28
3:28
![Хушнуд - Бевафо ёр (Премьера клипа 2025)]() 5:39
5:39
![Даша Эпова - Мой любимый человек (Премьера клипа 2025)]() 2:11
2:11
![Шохжахон Раҳмиддинов - Арзон (Премьера клипа 2025)]() 3:40
3:40
![Чёрный телефон 2 | Black Phone 2 (2025)]() 1:53:55
1:53:55
![Франкенштейн | Frankenstein (2025)]() 2:32:29
2:32:29
![Орудия | Weapons (2025)]() 2:08:34
2:08:34
![Только во сне | In Your Dreams (2025)]() 1:31:16
1:31:16
![Свинтусы | The Twits (2025)]() 1:42:50
1:42:50
![Только ты | All of You (2025)]() 1:38:22
1:38:22
![Рука, качающая колыбель | The Hand That Rocks the Cradle (2025)]() 1:44:57
1:44:57
![Большой куш / Спи#дили | Snatch (2000) (Гоблин)]() 1:42:50
1:42:50
![Супруги Роуз | The Roses (2025)]() 1:45:29
1:45:29
![Большое смелое красивое путешествие | A Big Bold Beautiful Journey (2025)]() 1:49:20
1:49:20
![Тот самый | Him (2025)]() 1:36:20
1:36:20
![Бешеные псы | Reservoir Dogs (1991) (Гоблин)]() 1:39:10
1:39:10
![Трон: Арес | Tron: Ares (2025)]() 1:52:27
1:52:27
![Убойная суббота | Playdate (2025)]() 1:34:35
1:34:35
![Протокол выхода | Exit Protocol (2025)]() 1:24:45
1:24:45
![Безжалостная | Stone Cold Fox (2025)]() 1:25:31
1:25:31
![Супергеройское кино | Superhero Movie (2008)]() 1:22:33
1:22:33
![Чумовая пятница 2 | Freakier Friday (2025)]() 1:50:38
1:50:38
![Мужчина у меня в подвале | The Man in My Basement (2025)]() 1:54:48
1:54:48
![Диспетчер | Relay (2025)]() 1:51:56
1:51:56
![Агент 203]() 21:08
21:08
![Супер Зак]() 11:38
11:38
![Карли – искательница приключений. Древнее королевство]() 13:00
13:00
![Хвостатые песенки]() 7:00
7:00
![Космический рейнджер Роджер Сезон 1]() 11:32
11:32
![Сборники «Приключения Пети и Волка»]() 1:50:38
1:50:38
![Пип и Альба Сезон 1]() 11:02
11:02
![Зебра в клеточку]() 6:30
6:30
![Оранжевая корова]() 6:30
6:30
![Сборники «Ну, погоди!»]() 1:10:01
1:10:01
![Команда Дино Сезон 1]() 12:08
12:08
![Истории Баданаму Сезон 1]() 10:02
10:02
![Минифорс. Сила динозавров]() 12:51
12:51
![Чемпионы]() 7:12
7:12
![Новогодние мультики – Союзмультфильм]() 7:04
7:04
![Приключения Тайо]() 12:50
12:50
![Отважные мишки]() 13:00
13:00
![Ну, погоди! Каникулы]() 7:09
7:09
![Панда и петушок Лука]() 12:12
12:12
![Псэмми. Пять детей и волшебство Сезон 1]() 12:17
12:17

 10:13
10:13Скачать Видео с Рутуба / RuTube
| 256x144 | ||
| 424x240 | ||
| 640x360 | ||
| 848x480 | ||
| 1280x720 |
 2:44
2:44
2025-11-20 21:37
 3:05
3:05
2025-11-25 11:19
 3:05
3:05
2025-11-25 11:25
 3:30
3:30
2025-11-13 11:12
 5:23
5:23
2025-11-21 13:15
 2:37
2:37
2025-11-23 13:33
 2:06
2:06
2025-11-11 18:00
 4:59
4:59
2025-11-15 12:21
 3:23
3:23
2025-11-19 11:51
 3:31
3:31
2025-11-14 19:59
 2:52
2:52
2025-11-20 13:43
 2:13
2:13
2025-11-15 12:35
 2:47
2:47
2025-11-19 11:44
 4:00
4:00
2025-11-21 13:29
 3:49
3:49
2025-11-15 12:54
 2:41
2:41
2025-11-12 12:48
 3:28
3:28
2025-11-20 13:54
 5:39
5:39
2025-11-23 13:40
 2:11
2:11
2025-11-15 12:28
 3:40
3:40
2025-11-21 13:31
0/0
 1:53:55
1:53:55
2025-11-05 19:47
 2:32:29
2:32:29
2025-11-17 11:22
 2:08:34
2:08:34
2025-09-24 22:05
 1:31:16
1:31:16
2025-11-21 20:18
 1:42:50
1:42:50
2025-10-21 16:19
 1:38:22
1:38:22
2025-10-01 12:16
 1:44:57
1:44:57
2025-10-29 16:30
 1:42:50
1:42:50
2025-09-23 22:53
 1:45:29
1:45:29
2025-10-23 18:26
 1:49:20
1:49:20
2025-10-21 22:50
 1:36:20
1:36:20
2025-10-09 20:02
 1:39:10
1:39:10
2025-09-23 22:53
 1:52:27
1:52:27
2025-11-06 18:12
 1:34:35
1:34:35
2025-11-19 10:39
 1:24:45
1:24:45
2025-11-13 23:26
 1:25:31
1:25:31
2025-11-10 21:11
 1:22:33
1:22:33
2025-11-21 14:16
 1:50:38
1:50:38
2025-10-16 16:08
 1:54:48
1:54:48
2025-10-01 15:17
 1:51:56
1:51:56
2025-09-24 11:35
0/0
 21:08
21:08
2025-01-09 16:39
2021-09-22 22:07
 13:00
13:00
2024-11-28 16:19
 7:00
7:00
2025-06-01 11:15
2021-09-22 21:49
 1:50:38
1:50:38
2025-10-29 16:37
2021-09-22 23:37
 6:30
6:30
2022-03-31 13:09
 6:30
6:30
2022-03-31 18:49
 1:10:01
1:10:01
2025-07-25 20:16
2021-09-22 22:29
2021-09-22 21:29
 12:51
12:51
2024-11-27 16:39
 7:12
7:12
2025-11-21 03:26
 7:04
7:04
2023-07-25 00:09
 12:50
12:50
2024-12-17 13:25
 13:00
13:00
2024-11-29 13:39
 7:09
7:09
2025-08-19 17:20
 12:12
12:12
2024-11-29 14:21
2021-09-22 22:23
0/0

